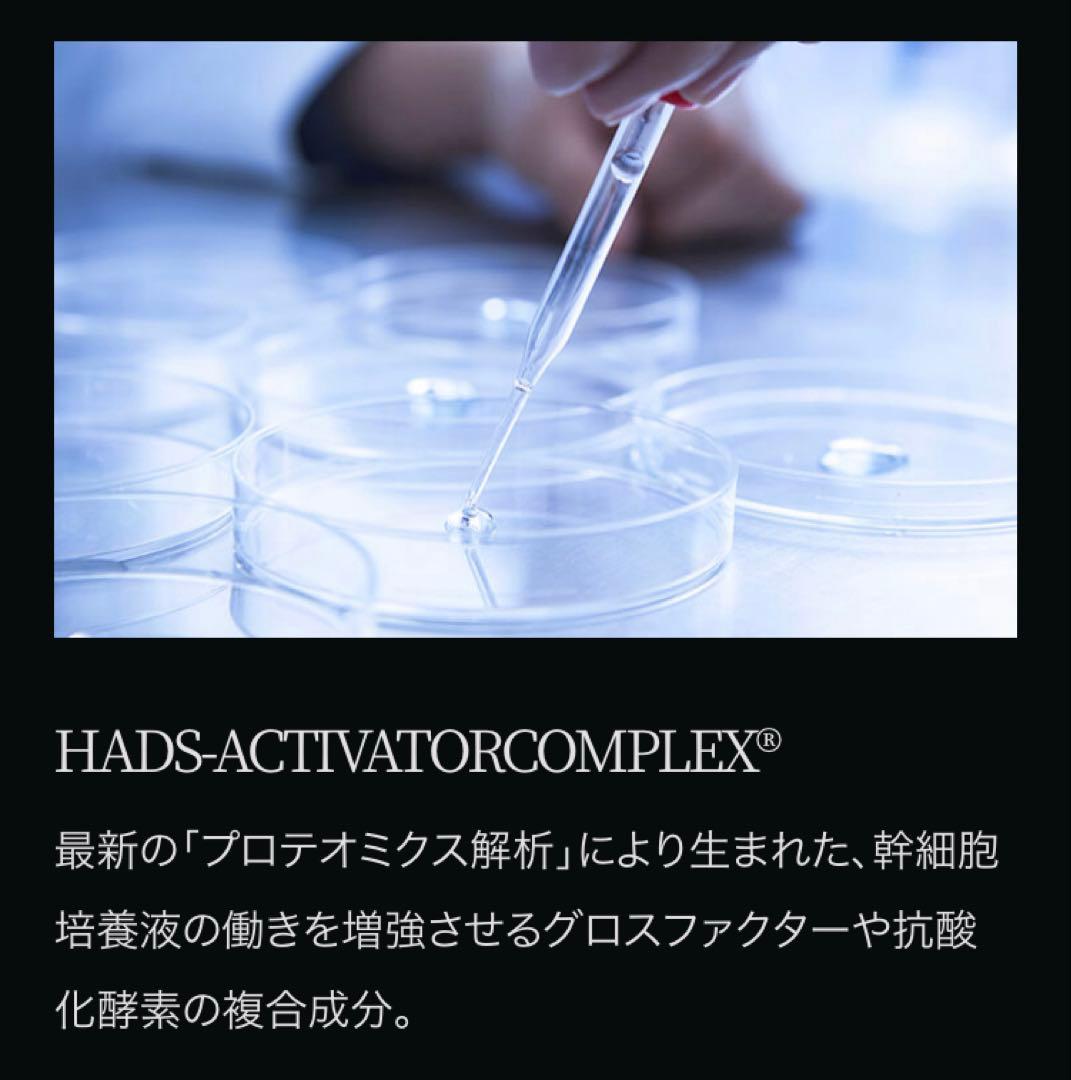
ディレイア　美容液　新品 ステムセラムEXソーム

マイストア
変更
お店で受け取る
(送料無料)
配送する
納期目安:
2026.03.17 21:57頃のお届け予定です。
決済方法が、クレジット、代金引換の場合に限ります。その他の決済方法の場合はこちらをご確認ください。
※土・日・祝日の注文の場合や在庫状況によって、商品のお届けにお時間をいただく場合がございます。
ディレイア 美容液 新品 ステムセラムEXソームの詳細情報
ディレイア 美容液 新品ステムセラムEXソームソーム★発送・お値下げ交渉本業が忙しく、やり取りの時間が難しいためお値引き交渉はご遠慮下さい。Mousa LU Serum 3本セット。お値段そのため極限まで下げております。ニコちゃん☺️。サロン価¥23100明石家さんまさん司会「ほんまでっかTV」でもと実際に紹介された商品がこちらです。POLA B.A MEN ザ セラム リフィル 90mL 2個。シミ・しわ・たるみ・くすみ・ほうれい線などが気になる方にヒト幹細胞培養液美容液、EGF、プラセンタエキス等入った高級美容液です有名高級エステサロンで実際に使用されている商品です。POLA ポーラ ホワイトショット フェイシャルセラム。私も愛用しております。エンビロンCクエンストーナー Cクエンスセラム3。美肌 美白 肌質改善 ●本業が忙しくフリマはその合間にしております。ルビーセルエクソナインダーマコードインフュージョンセラム1箱⭐️未使用品⭐️。こちら都合で申し訳ございませんが、やりとりの時間が難しいのでお値下げ交渉はご遠慮下さい。資生堂 クレ・ド・ポー ボーテ CPB セラムエクラS 40mL。そのためお値段は極限まで下げております。ル・セラムII 75m。●他出品のもの、他ご希望本数同時配送の場合、割引ありますのでメッセージください。シャチです。。●箱なし出品などは模造品の可能性高いですご注意下さい。DREXELドレクセルセラムマキシマイザー美容液30mL5本セット。●ステムリペアクレンジング・プロテクトUV●BBクリーム●アイラッシュザステムセラム●シャンプー&コンディショナー●ステムプラチナムバイオマスク●ステムインテンスユースローション120ml 150ml●ステムアンペリティザクリーム●美容液●ディープスベルティルメソボディクリーム●フィックスリフトメソクリーム●ステム リペア クレンジング 150ml種類···美容液/セラム成分···ヒト幹細胞成分···グロスファクター
ベストセラーランキングです
近くの売り場の商品
カスタマーレビュー
オススメ度 4.4点
現在、3664件のレビューが投稿されています。